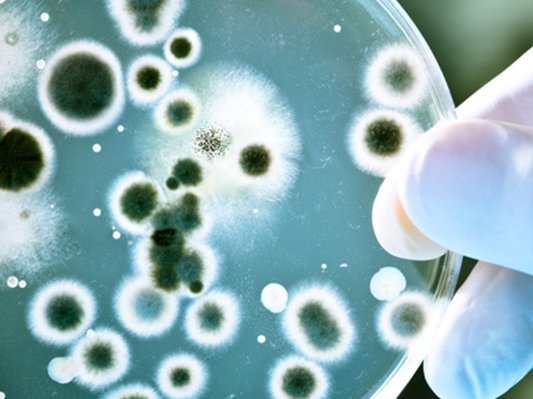
Es liegt was in der Luft … ein schutzbringender Duft Es liegt was in der Luft … ein schutzbringender Duft

Newsroom Integrative Medizin
Gemeinsam für eine Medizin der Zukunft!
Wir informieren Sie über Neuigkeiten aus Wissenschaft und Forschung zur Integrativen Medizin.
Hier finden Sie Studien und Metaanalysen, Reportagen aus der Welt der Komplementärmedizin und Naturheilkunde, Buchbesprechungen oder auch Personalia und Anzeigen.
Gemeinsam für eine Medizin der Zukunft!
Weiter unten auf dieser Seite können Sie alle Artikel filtern nach Schlagworten oder Rubriken.